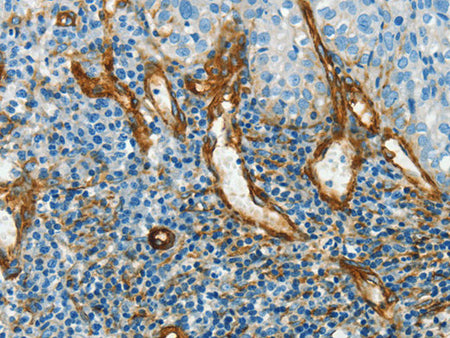
CAV1 Polyclonal Antibody Store at -20°C

CAV1 Polyclonal Antibody Store at -20°C
Couldn't load pickup availability

Still have questions? Ask our experts!
CAV1 Polyclonal Antibody Store at -20°C
| SKU # | E-AB-13048 |
| Reactivity | Human, Mouse, Rat |
| Host | Rabbit |
| Applications | WB, IHC |
Product Details
| Isotype | IgG |
| Host | Rabbit |
| Reactivity | Human, Mouse, Rat |
| Applications | WB, IHC |
| Clonality | Polyclonal |
| Immunogen | Synthetic peptide of human CAV1 |
| Abbre | CAV1 |
| Synonyms | 22 kD, BSCL3, CAV, CAV1, CGL3, Caveolin 1 caveolae protein 22kDa, Caveolin-1, Caveolin1, LCCNS, MSTP085, OTTHUMP00000025031, PPH3, VIP 21, VIP21, caveolae protein, caveolin 1 alpha isoform, caveolin 1 beta isoform, cell growth-inhibiting protein 32 |
| Swissprot | |
| Calculated MW | 20 kDa |
| Cellular Localization | Golgi apparatus membrane. Cell membrane. Membrane>caveola. Membrane raft. Colocalized with DPP4 in membrane rafts. Potential hairpin-like structure in the membrane. Membrane protein of caveolae. |
| Concentration | 0.5 mg/mL |
| Buffer | Phosphate buffered solution, pH 7.4, containing 0.05% stabilizer and 50% glycerol. |
| Purification Method | Affinity purification |
| Research Areas | Cancer, Cardiovascular, Metabolism, Signal Transduction, Tags and Cell Markers |
| Conjugation | Unconjugated |
| Storage | Store at -20°C Valid for 12 months. Avoid freeze / thaw cycles. |
| Shipping | The product is shipped with ice pack,upon receipt,store it immediately at the temperature recommended. |
Related Reagents
| Applications | Recommended Dilution |
| WB | 1:1000-1:5000 |
| IHC | 1:50-1:200 |
Background
The scaffolding protein encoded by this gene is the main component of the caveolae plasma membranes found in most cell types. The protein links integrin subunits to the tyrosine kinase FYN, an initiating step in coupling integrins to the Ras-ERK pathway and promoting cell cycle progression. The gene is a tumor suppressor gene candidate and a negative regulator of the Ras-p42/44 mitogen-activated kinase cascade. Caveolin 1 and caveolin 2 are located next to each other on chromosome 7 and express colocalizing proteins that form a stable hetero-oligomeric complex. Mutations in this gene have been associated with Berardinelli-Seip congenital lipodystrophy. Alternatively spliced transcripts encode alpha and beta isoforms of caveolin 1.